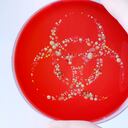
Meningitis

El colesterol es una sustancia cerosa necesaria en cantidades moderadas para la producción de hormonas, vitamina D y otras funciones indispensables para la salud del cuerpo. El organismo se encarga de producir los niveles adecuados de este compuesto; sin embargo, sus valores se elevan cuando una persona lleva un plan de alimentación rico en grasas saturadas y trans.
Cuando los niveles de colesterol se encuentran elevados, esta grasa se acumula en las paredes de las arterias, impidiendo la libre circulación de la sangre; lo que a largo plazo puede detonar en un infarto u otras afecciones que pueden perjudicar la salud del corazón.
Según la Fundación Española del Corazón, este lípido se produce, en su mayoría, en el órgano interno más grande del cuerpo, el hígado, aunque también se puede obtener cuando se consumen determinados alimentos.

Alimentos que debe consumir una persona con el colesterol alto
Una persona que padece de esta enfermedad debe hacerse los chequeos médicos que estipule el profesional de la salud; en algunos casos, el paciente, debe consumir un medicamento para regular los niveles de colesterol en la sangre; sin embargo, la alimentación y la práctica de actividad física frecuente juegan un papel importante a la hora de mejorar las condiciones de salud de un paciente que padece de colesterol alto.
Terra en su sección de salud y cuidado personal brinda la lista de algunos productos y alimentos que pueden ser involucrados en el plan de alimentación de una persona que padece de colesterol alto; estos alimentos cuentan con propiedades antioxidantes que ayudarán a regular sus niveles y a aumentar el colesterol bueno que también está presente en la sangre.
- Almendras: diversos estudios han demostrado que cada 100 gramos de este fruto seco cuenta con 60 gramos de grasas saludables, 19 gramos de proteína, 8,3 gramos de fibra, magnesio y vitaminas; por ende, este puede ser un alimento indispensable en la dieta de las personas que desean bajar sus niveles de colesterol en la sangre. Estos frutos secos pueden estar presentes en las primeras horas del día, bien sea en el desayuno o como un snack en la media mañana.
- Aguacate: este es otro alimento que si se consume en cantidades moderadas le proporciona grasas saludables al cuerpo; estas son esenciales para disminuir los niveles de colesterol malo y aumentar los buenos. “Según una investigación desarrollada en 2015 y publicada en Journal of the American Heart Association, una porción de aguacate por día reduce los niveles de colesterol alto en personas con sobrepeso y obesidad”.

- Avena: este cereal no puede faltar en la dieta de ninguna persona, este alimento contiene fibra soluble e insoluble; por ende, reduce de manera natural el colesterol que sea acumulado en las arterias; además, gracias a su contenido de fibra mejora la digestión, ayudando a prevenir y combatir el estreñimiento.
- Zanahoria: gracias a su alto contenido de vitamina C; este alimento reduce los niveles de colesterol malo en la sangre. Además, las personas que padecen de diabetes también obtendrán beneficios al consumir este alimento, ya que gracias a su alto contenido de betacarotenos, la zanahoria tiene la capacidad de reducir los niveles elevados de azúcar en la sangre.